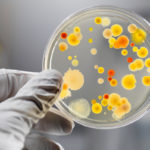

Pöyry and Betulium sign co-operation agreement to unlock full value chain benefits for clients in bio-based businesses
news

Edipap Srl | VAT IT09057310964 | Via Pordenone 13, 20132 - Milan - Italy | phone +39 02 21711614 | www.edipap.com | info@papnews.com
close and go back to site